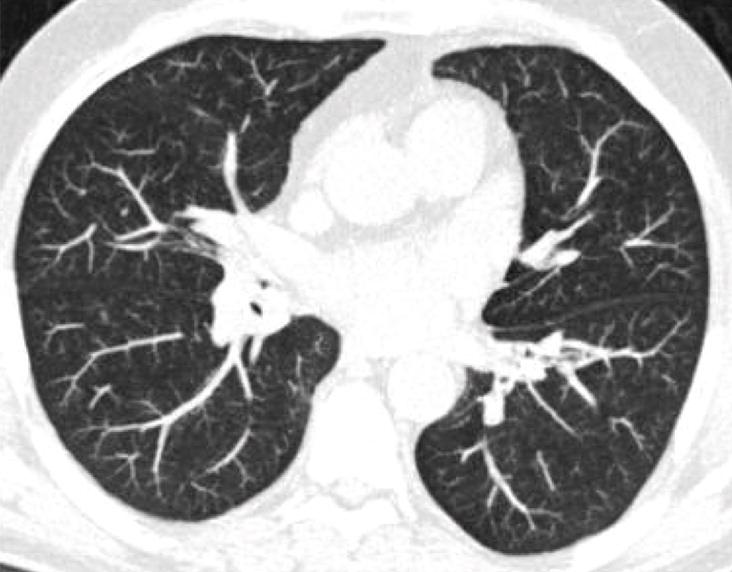

Features of Resolving and Nonresolving Indeterminate Pulmonary Nodules at Follow-up CT: The NELSON Study
Background
- 66% of participants in CT screening trials have at least 1 pulmonary nodule
- Most indeterminate nodules benign
- granulomatous or infectious lesions
- benign lymph nodes
- Purpose: to retrospectively identify features allowing prediction of disappearance of solid, indeterminate intraparenchymal nodules
The NELSON Study
Nodule management based on volume and volume doubling time
Population
- 7557 participants
- 46-76 years old (mean age 59)
- high risk for lung cancer
- current or former smokers
- > 15 pack years
CT protocol
- 1.0 mm slice thickness, low dose
- baseline, 1 year, 3 years
- If indeterminate nodule found,
followup scan at 3 months
-
No growth or < 25% growth:
- regular screening
- > 25% growth or volume doubling time < 400 days:
- referred for further workup
Image Reading
- Read twice independently
- 1st by one of 13 radiologists 1-20 yrs experience
- 2nd by one of 2 radiologists at least 6 yrs experience
- If discrepancy
- 3rd radiologist > 15 yrs experience arbitrated
Volume calculation
- Syngo Lungcare software package
- 3D template generated after clicking nodule with automated volume measurements
- In 86% of >4000 nodules, double reading gave same volume
- Differences >15% found in 4% of nodules
- If volumes differed, 2nd reader measurements used
Nodule characteristics
- Indeterminate size:
- 50 - 500 mm^3 (4.6 - 9.8 mm)
- Considered benign if no growth after 2 years
or benign histology - Considered resolved if disappeared on followup CT
- Peripheral defined as outer 1/3 of lung
- Margins defined as smooth vs.
non-smooth (lobulated, irregular, spiculated)
Results: Figure 1

Results: Table 1

Results: Table 2

Results: Table 3

Results: Table 4

Results: Figure 2 (smooth, round)

Results: Figure 2 (lobulated)



Discussion
In NELSON, 10.7% of participants had solid, intraparenchymal nodule with volume 50-500 mm^3
10.1% disappeared at followup
Though most do not resolve, 75% of those that do resolve can be identified at 3-month repeat CT
Discussion
Discussion
The rate and speed of disappearance higher for larger nodules (>= 8 mm)
However, rate of malignancy also higher
May be explained by benign conditions like inflammation commonly showing nodules with a larger diameter
Limitations
Precise time of nodule resolution could not be ascertained
No histology for resolving nodules
Generalizability to incidental nodules found on non-screening exams
Conclusions
About 10% of solid intraparenchymal nodules of intermediate size resolve during followup
Short term followup CT valuable for detecting fast-growing nodules and for identifying 3/4 of resolving nodules
Resolving pulmonary nodules share CT features with malignant nodules.